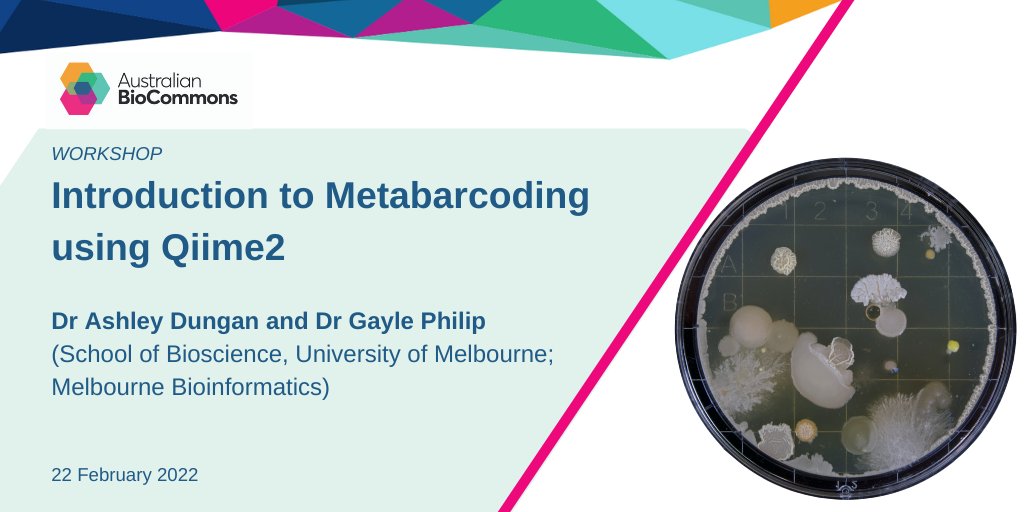
AusBiocommons's tweet image. Explore a whole new world of the #microbiome

Find out how to use Qiime2 to conduct #MicrobiomeAnalysis and discover different microbial communities in our @qiime2 workshop

Thanks to @MelBioInf

22 February, 1-5pm AEDT

biocommons.org.au/events/metabar…

#microbiomeanalysis search results
Join our 𝟐-𝐃𝐚𝐲 𝐇𝐚𝐧𝐝𝐬-𝐎𝐧 𝐈𝐧𝐭𝐞𝐫𝐚𝐜𝐭𝐢𝐯𝐞 𝐎𝐧𝐥𝐢𝐧𝐞 𝐖𝐨𝐫𝐤𝐬𝐡𝐨𝐩 - 𝐂𝐥𝐢𝐧𝐢𝐜𝐚𝐥 𝐌𝐢𝐜𝐫𝐨𝐛𝐢𝐨𝐦𝐞 𝐀𝐧𝐚𝐥𝐲𝐬𝐢𝐬 🔗 𝑹𝒆𝒈𝒊𝒔𝒕𝒆𝒓 𝒏𝒐𝒘: forms.gle/NYF5bEe5M6r34D…. #MicrobiomeAnalysis #16SRNA #Bioinformatics #ClinicalMicrobiome #DataScience




Microbiome Analysis & Gut Health? #BioAro #MicrobiomeAnalysis #GutHealth #health #genetic #gutmicrobiome #bacteria #genomics #genomicstesting #canada

✨Planning your next project? Our streamlined online form makes it easy to request a tailored quote. Share a few details and our team will get back to you quickly with a quote. 👉 seqbiome.com/get-a-quote/ #microbiomeanalysis #bioinformatics #SportGenix #clinicalresearch #GutHealth
Don’t miss the occasion! Contact us lnkd.in/dKuW7zHd #metagenomics #metabarcoding #microbiomeanalysis #16Ssequencing

🔍 Every solid analysis starts with the right question. We help you craft testable, well-powered research hypotheses—unlocking insights through the best methods and tech. Explore Compositional & Functional #MicrobiomeAnalysis with us today! ttps://seqbiome.com/solutions/ #gut
🔍 "Adaptive adjustment of profile HMM significance thresholds improves functional and metabolic insights into microbial genomes" is available in Bioinformatics Advances: doi.org/10.1093/bioadv… #MicrobialGenomics #FunctionalAnnotation #MicrobiomeAnalysis Authors include:…

🔬Join our 𝟒-𝐃𝐚𝐲 𝐇𝐚𝐧𝐝𝐬-𝐎𝐧 𝐎𝐧𝐥𝐢𝐧𝐞 𝐖𝐨𝐫𝐤𝐬𝐡𝐨𝐩 𝐨𝐧 𝐌𝐞𝐭𝐚𝐠𝐞𝐧𝐨𝐦𝐢𝐜𝐬 & 𝐍𝐆𝐒 🚀 🔗 𝗥𝗲𝗴𝗶𝘀𝘁𝗲𝗿 𝗡𝗼𝘄: forms.gle/oi66kaGMiCN5gJ… 📍 #Metagenomics 🧫 #NGS #MicrobiomeAnalysis #Bioinformatics #Genomics #NGSWorkshop #16SrRNA
Busy week for our CTO @ProfPaulCotter! 🎤 Mon: Presenting in Rome Wed: Discussing milk microbiome research in Aarhus, Denmark. #microbiota #microbiomeanalysis #microbiomeresearch #microbiomesequencing #nutrition #clinicalresearch #Metabolomics #clinicaltrials #sportGenix

Struggling with the sequencing report? Our latest blog, "Seven Key Analytical Components in Microbiome Analysis," has got you covered! metwarebio.com/key-analytical… #MicrobiomeAnalysis #DataAnalytics

Last week, I attended the Microbiome Data Science course with #R and #Bioconductor, taught by Prof. Leo Lahti, with assistance from Izabela Mamede and João P. Almeida. Great opportunity to enhance my microbiome data processing skills! #MicrobiomeAnalysis #RStats

From quality control to in-depth analysis, our #bioinformatics pipelines are developed for the cloud, allowing us to scale workloads to the client’s needs. ttps://seqbiome.com/solutions/biostatistical-and-bioinformatic-analysis/ #microbiota #microbiomeanalysis #clinicalresearch
Optimization of the #gutMicrobiome, through a high quality #microbiomeAnalysis program, can enhance #athletic performance. SportGenix is a program designed for #performanceNutritionists that want to provide their #eliteAthletes with the most up-to-date recommendations.
We explored the #mia (lnkd.in/egABVqM3) and #miaViz (lnkd.in/eW6k66aT) packages, which offer powerful tools for microbiome analysis and visualization. A valuable addition to my toolbox! #MicrobiomeAnalysis #RStats

We’re looking forward to connecting with our customers & partners at @MicrobiomeTimes Partnering Forum in Brussels next week! If you’re interested in #MicrobiomeAnalysis, don’t miss the opportunity to meet with our CEO, Dr. David Corr! #clinicalresearch #microbiomeresearch
Visualize Microbial Patterns with PCA (Principal Component Analysis) With over 10 years of microbiome expertise, #BMKGENE transforms your raw data into clear PCA insights and beyond. #Bioinformatics #MicrobiomeAnalysis #DataVisualization #PCA #BetaDiversity

SPECIAL OFFER! Gut & Soil #MicrobiomeAnalysis Learn more: 22417979.hs-sites.com/microbiome-ana… #microbiome #sequencing

"🔬 Dive into the world of Microbiome Analysis with our hands-on Metagenomics Workshop! 🧫🧪 Join us online on 17th September 2023 for an exciting journey into understanding microbial communities. Don't miss out! #MetagenomicsWorkshop #MicrobiomeAnalysis #ScienceOnline"

Metagenomic Sequencing Market Size, Share, Demand, Growth and Global Industry Analysis 2034 To Know More : linkedin.com/pulse/metageno… #metagenomics #genomicsresearch #microbiomeanalysis #biotechinnovation #nextgensequencing
linkedin.com
Metagenomic Sequencing Market Size, Share, Demand, Growth and Global Industry Analysis 2034
Metagenomic Sequencing Market is projected to expand at a strong CAGR of 15.4%, from $3.
Have you taken us up on our special offer yet? Back by popular demand, we've extended our partnership with @CRiverLabs to offer you 2 FREE #MicrobiomeTests for every rat or mouse strain you order from CRL! Click the link below to get yours!🧬👇🏽 #MicrobiomeAnalysis

Revolutionizing Health Through AI: Transforming Microbiome Analysis and Personalized Nutrition #AIHealthcare #MicrobiomeAnalysis #PersonalizedNutrition #GeneticData #HealthTech #HolisticWellness #FutureOfHealthcare #AIInnovation #HealthRevolution #OptimalNutrition
Join our 𝟐-𝐃𝐚𝐲 𝐇𝐚𝐧𝐝𝐬-𝐎𝐧 𝐈𝐧𝐭𝐞𝐫𝐚𝐜𝐭𝐢𝐯𝐞 𝐎𝐧𝐥𝐢𝐧𝐞 𝐖𝐨𝐫𝐤𝐬𝐡𝐨𝐩 - 𝐂𝐥𝐢𝐧𝐢𝐜𝐚𝐥 𝐌𝐢𝐜𝐫𝐨𝐛𝐢𝐨𝐦𝐞 𝐀𝐧𝐚𝐥𝐲𝐬𝐢𝐬 🔗 𝑹𝒆𝒈𝒊𝒔𝒕𝒆𝒓 𝒏𝒐𝒘: forms.gle/NYF5bEe5M6r34D…. #MicrobiomeAnalysis #16SRNA #Bioinformatics #ClinicalMicrobiome #DataScience




✨Planning your next project? Our streamlined online form makes it easy to request a tailored quote. Share a few details and our team will get back to you quickly with a quote. 👉 seqbiome.com/get-a-quote/ #microbiomeanalysis #bioinformatics #SportGenix #clinicalresearch #GutHealth
Busy week for our CTO @ProfPaulCotter! 🎤 Mon: Presenting in Rome Wed: Discussing milk microbiome research in Aarhus, Denmark. #microbiota #microbiomeanalysis #microbiomeresearch #microbiomesequencing #nutrition #clinicalresearch #Metabolomics #clinicaltrials #sportGenix

Visualize Microbial Patterns with PCA (Principal Component Analysis) With over 10 years of microbiome expertise, #BMKGENE transforms your raw data into clear PCA insights and beyond. #Bioinformatics #MicrobiomeAnalysis #DataVisualization #PCA #BetaDiversity

🎉 Happy Birthday to Frontiers in Microbiology! Big congrats to our CTO Prof. @pauldcotter , also Field Chief Editor. Frontiers is now one of the most cited journals in microbiology—what a milestone! #ResearchExcellence #sportGenix #microbiomeanalysis
It's our big day! Frontiers in Microbiology is 15 years old 🎉 Huge thank you to @pauldcotter, all our Chief Editors and the #microbiology community for their support to get us where we are now as the most cited journal in the field 🦠 Here's to another 15 years - see how you…

🔬Join our 𝟒-𝐃𝐚𝐲 𝐇𝐚𝐧𝐝𝐬-𝐎𝐧 𝐎𝐧𝐥𝐢𝐧𝐞 𝐖𝐨𝐫𝐤𝐬𝐡𝐨𝐩 𝐨𝐧 𝐌𝐞𝐭𝐚𝐠𝐞𝐧𝐨𝐦𝐢𝐜𝐬 & 𝐍𝐆𝐒 🚀 🔗 𝗥𝗲𝗴𝗶𝘀𝘁𝗲𝗿 𝗡𝗼𝘄: forms.gle/oi66kaGMiCN5gJ… 📍 #Metagenomics 🧫 #NGS #MicrobiomeAnalysis #Bioinformatics #Genomics #NGSWorkshop #16SrRNA
🔍 Every solid analysis starts with the right question. We help you craft testable, well-powered research hypotheses—unlocking insights through the best methods and tech. Explore Compositional & Functional #MicrobiomeAnalysis with us today! ttps://seqbiome.com/solutions/ #gut
The #SportGenix Athlete Microbiome Report integrates patient history with advanced #MicrobiomeAnalysis providing #PerformanceNutritionists with evidence-based recommendations for their #EliteAthletes 👉Request a sample report sportgenix.ie/request-a-samp… #MicrobiomeSequencing
Optimization of the #gutMicrobiome, through a high quality #microbiomeAnalysis program, can enhance #athletic performance. SportGenix is a program designed for #performanceNutritionists that want to provide their #eliteAthletes with the most up-to-date recommendations.
We explored the #mia (lnkd.in/egABVqM3) and #miaViz (lnkd.in/eW6k66aT) packages, which offer powerful tools for microbiome analysis and visualization. A valuable addition to my toolbox! #MicrobiomeAnalysis #RStats

Last week, I attended the Microbiome Data Science course with #R and #Bioconductor, taught by Prof. Leo Lahti, with assistance from Izabela Mamede and João P. Almeida. Great opportunity to enhance my microbiome data processing skills! #MicrobiomeAnalysis #RStats

🔍 "Adaptive adjustment of profile HMM significance thresholds improves functional and metabolic insights into microbial genomes" is available in Bioinformatics Advances: doi.org/10.1093/bioadv… #MicrobialGenomics #FunctionalAnnotation #MicrobiomeAnalysis Authors include:…

We’re looking forward to connecting with our customers & partners at @MicrobiomeTimes Partnering Forum in Brussels next week! If you’re interested in #MicrobiomeAnalysis, don’t miss the opportunity to meet with our CEO, Dr. David Corr! #clinicalresearch #microbiomeresearch
Contact us igatechnology.com/igatech/contac… #metagenomics #metabarcoding #microbiomeanalysis #16Ssequencing

Don’t miss the occasion! Contact us lnkd.in/dKuW7zHd #metagenomics #metabarcoding #microbiomeanalysis #16Ssequencing

Microbiome Analysis & Gut Health? #BioAro #MicrobiomeAnalysis #GutHealth #health #genetic #gutmicrobiome #bacteria #genomics #genomicstesting #canada

#Metabarcoding on NovaSeq? Why not! Discover advantages bit.ly/3pZIhKj #microbiomeanalysis #metagenomics #taxonomicclassification #biodiversity #eDNA #NGS

Don’t miss the occasion! Contact us igatechnology.com/igatech/contac… #metagenomics #metabarcoding #microbiomeanalysis #16Ssequencing

When your first lot of sequencing data has some interesting and promising results #microbiomeanalysis #16Ssequencing #Bioinformatics #chickenology
🔍 "Adaptive adjustment of profile HMM significance thresholds improves functional and metabolic insights into microbial genomes" is available in Bioinformatics Advances: doi.org/10.1093/bioadv… #MicrobialGenomics #FunctionalAnnotation #MicrobiomeAnalysis Authors include:…

Qiime2: silence is golden Me (every hour today): are you still doing what I asked you? #impatientscientist #Microbiomeanalysis #bioinformatics
Join our 𝟐-𝐃𝐚𝐲 𝐇𝐚𝐧𝐝𝐬-𝐎𝐧 𝐈𝐧𝐭𝐞𝐫𝐚𝐜𝐭𝐢𝐯𝐞 𝐎𝐧𝐥𝐢𝐧𝐞 𝐖𝐨𝐫𝐤𝐬𝐡𝐨𝐩 - 𝐂𝐥𝐢𝐧𝐢𝐜𝐚𝐥 𝐌𝐢𝐜𝐫𝐨𝐛𝐢𝐨𝐦𝐞 𝐀𝐧𝐚𝐥𝐲𝐬𝐢𝐬 🔗 𝑹𝒆𝒈𝒊𝒔𝒕𝒆𝒓 𝒏𝒐𝒘: forms.gle/NYF5bEe5M6r34D…. #MicrobiomeAnalysis #16SRNA #Bioinformatics #ClinicalMicrobiome #DataScience




You've got maiiiiiil! (You really should read this one if you're keen to learn more about #16S #microbiomeanalysis) Newsletter #14: Beginners guide to 16S microbial analysis 📊 - mailchi.mp/61803e4079cd/n…
Struggling with the sequencing report? Our latest blog, "Seven Key Analytical Components in Microbiome Analysis," has got you covered! metwarebio.com/key-analytical… #MicrobiomeAnalysis #DataAnalytics

The last day of #summerschool starts with lectures on 👉#MicrobiomeAnalysis and networks - @HusonDaniel 👉#MetabolicNetworks and #Ecosystems - @markobudinich 👉Nature as #networks - Marc-André Sélosse

To help you obtain the best results from your analysis, we offer a completely personalized consulting service, including scientific and technical advice. Find out more bit.ly/2X4Q3Tx #WorldMicrobiomeDay #metagenomics #microbiomeanalysis #MindOurMicrobes #bioinformatics

LIMITED-TIME OFFER! 🧬 Don't forget - you can claim two FREE microbiome tests for every rat or mouse strain you order from @CRiverLabs! Order yours today and gain invaluable insights: info.transnetyx.com/criver-microbi… #microbiomeanalysis #microbiomeresearch

Interested in working with companies that are leveraging the microbiome to treat disease and improve human health? Click the link to share innovations with aligned R&D teams open to conversations and partnerships: in-part.com/global-challen… #MicrobiomeResearch #MicrobiomeAnalysis

Don't miss out! This is your last chance to sign up for our new workshop and learn how to use @qiime2 to conduct #MicrobiomeAnalysis Applications close tomorrow, Tuesday 8th February 6pm AEDT! Thanks to @Symb10sis and @BioSci_UniMelb @MelBioInf biocommons.org.au/events/metabar…

Research reproducibility matters! At Transnetyx, we believe every researcher should have the most efficient path to discovery. So, we're offering 5 FREE #GENOTYPING SAMPLES through April when you order a Transnetyx #MicrobiomeAnalysis test! Claim yours: info.transnetyx.com/mb-offer-2023

SPECIAL OFFER! Gut & Soil #MicrobiomeAnalysis Learn more: 22417979.hs-sites.com/microbiome-ana… #microbiome #sequencing

Last week, I attended the Microbiome Data Science course with #R and #Bioconductor, taught by Prof. Leo Lahti, with assistance from Izabela Mamede and João P. Almeida. Great opportunity to enhance my microbiome data processing skills! #MicrobiomeAnalysis #RStats

Explore a whole new world of the #microbiome Find out how to use Qiime2 to conduct #MicrobiomeAnalysis and discover different microbial communities in our @qiime2 workshop Thanks to @MelBioInf 22 February, 1-5pm AEDT biocommons.org.au/events/metabar…
Something went wrong.
Something went wrong.
United States Trends
- 1. #IDontWantToOverreactBUT N/A
- 2. $ENLV 9,246 posts
- 3. Jimmy Cliff 17.3K posts
- 4. #GEAT_NEWS N/A
- 5. Thanksgiving 136K posts
- 6. #MondayMotivation 11.6K posts
- 7. Victory Monday 3,125 posts
- 8. Good Monday 46.8K posts
- 9. TOP CALL 4,628 posts
- 10. $GEAT N/A
- 11. DOGE 216K posts
- 12. #WooSoxWishList N/A
- 13. Monad 157K posts
- 14. The Harder They Come 2,307 posts
- 15. #MondayVibes 3,116 posts
- 16. AI Alert 2,615 posts
- 17. Market Focus 3,122 posts
- 18. Bowen 15.1K posts
- 19. $NVO 3,318 posts
- 20. Check Analyze N/A




















